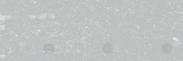
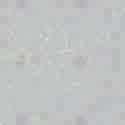
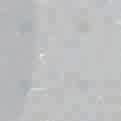
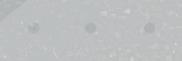
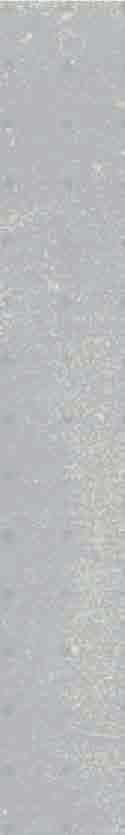

FALL/WINTER 2025









![]()


























































FALL/WINTER 2025

























marcó la introducción del color en el fútbol. Fructuoso López lanzó en los años noventa las primeras botas de color. Dejaron de ser negras para teñirse de otros colores y revolucionar para siempre el terreno de juego.
The turning point in the company’s growth was marked by the introduction of color in football. Fructuoso López launched the first colored boots in the 1990s. They stopped being black to be dyed in other colors and
“EN 1965 FUNDÉ JOMA CON EL COMPROMISO DE DEDICARLE A LA EMPRESA TODO MI ESFUERZO, TIEMPO Y CARIÑO. 50 AÑOS DESPUÉS, ESO ES EXACTAMENTE LO QUE HACEMOS”
“In 1965 founded Joma, with the commitment to devote all of my effort, time and affection to the company. 50 years later, that is exactly what we do.”
En 2017 Joma implementa una nueva maquinaria robótica en su almacén logístico internacional con el objetivo de agilizar el trabajo, desde el almacenamiento de los productos hasta la preparación de paquetes para enviar a cualquier parte del mundo. Consigue entregar un 87% de las ventas antes de la fecha prevista, reduciendo el margen de error al 1%.
In 2017, Joma implements new robotic machinery in its international logistics warehouse with the aim of streamlining work, from product storage to package preparation for shipment worldwide. It manages to deliver 87% of sales before the scheduled date, reducing the margin of error to 1%.



En 1965 nace Joma y en 1969 se instala la primera cadena de montaje con 20 empleados. Joma is born in 1965 and in 1969 the first assembly line is installed with 20 employees.
La distribución del producto de Joma se amplía a más de 120 países. Esto hace que alcance la posición de primera marca deportiva española y que entre en el top 10 mundial. También inicia la apertura de tiendas propias y córners.
Joma’s product to more than 120 countries. This makes it the leading Spanish sports brand and enters the top 10 worldwide. It also starts opening its own stores and corners.

Joma se enfrenta al reto de la globalización y asiste por primera vez a la ISPO de Múnich, la feria europea más importante del sector deportivo.

Joma faces the challenge of globalization and attends the the most important European fair in the sports sector.

Joma lanza en 1996 la campaña “EL COLOR EN EL FÚTBOL” y revoluciona el mercado mundial de botas de fútbol. Alfonso luce las botas blancas, Morientes sorprende con las rojas.
Joma launches the campaign “COLOR IN FOOTBALL” in 1996 and revolutionizes the global market for football boots. Alfonso wears white boots, Morientes surprises with red ones.



En los Juegos Olímpicos de Tokio 2020, Joma viste a más de 1.500 atletas procedentes de 12 países, incluyendo España, Portugal, Marruecos, Jordania, Kazajistán, Honduras, Malta y Mauricio.
At the Tokyo 2020 Olympic Games, Joma outfits over 1,500 athletes from 12 countries, including Spain, Portugal, Morocco, Jordan, Kazakhstan, Honduras, Malta, and Mauritius.

Joma investiga y desarrolla para lograr que todas sus tecnologías sean propias. La calidad es su razón de ser.
Joma researches and develops to ensure that all its technologies are proprietary. Quality is its reason for being.


Joma entra en los JJ.OO. de Río 2016 vistiendo a un 10% de los deportistas, entre los que se encuentran 18 federaciones, el COE y otros 8 comités.
Además, ya cuenta con 10 filiales en España, Italia, Noruega, Dinamarca, China y Rusia y un crecimiento anual del 20%. Este mismo año, alcanza los 4 millones
Joma enters the Rio 2016 Olympics dressing 10% of the athletes, including 18 federations, the COE, and 8 other committees.
It also already has 10 subsidiaries in Spain, Italy, the Norway, Denmark, China, and Russia and an annual growth of 20%. This same year, it reaches 4 million




Durante el 2023, Joma sufre de su historia. El impulso del concepto Brand Store le lleva a alcanzar una potente presencia nacional e internacional. Además, comienza su estrategia de renovación absoluta del diseño interior y de optimización del espacio. internacional y amplía su venta a más de 140 países gracias a su estrategia para elevar la imagen de marca y a su creciente inversión en I+D+i. Durante los Juegos Olímpicos de París, bate récord de presencia vistiendo al 15% de los atletas y se mayor representación.
in its history. The momentum of the Brand Store concept leads it to achieve a strong national and international presence. Additionally, it begins its strategy of complete interior design renovation and space optimization.
The brand undergoes a new its sales to over 140 countries thanks to its strategy to enhance the brand image and its growing investment in R&D. During the Paris Olympics, it sets a record for presence by becomes the Spanish company with the highest representation.







Primera zapatilla de competición de Trail: TREK.


Joma crea las zapatillas SIERRA y SIMA, dos de los modelos de trail más icónicos de la marca.



PRIMEROS CORREDORES compitiendo con JOMA en carreras Trail.

2018
Joma patrocina su primera carrera de Trail en DESAFÍO URBION.







Se crea el concepto TR-9000 tras el éxito de la zapatilla de asfalto R-4000.


Lanzamiento de la primera zapatilla de la gama TR: TR-9000
2017 2019 2023




Primera presencia de stand Joma en carrera de Trail en VAL D’ ARAN






Joma refuerza su presencia en trail con un equipo oficial de 16 personas y los fichajes de MIGUEL HERAS o GEMMA ARENAS leyendas del trail nacional, entre otros. Joma compite y se concentra como equipo por primera vez en ULTRAPIRINEU
























En los últimos años, Joma ha intensificado su inversión en I+D+i con el objetivo de integrar tecnología avanzada en sus productos, respondiendo así a las crecientes demandas del mercado deportivo y de los consumidores. La marca ha sido capaz de destinar cada vez más recursos hacia el desarrollo de nuevos materiales y procesos de fabricación que optimizan la funcionalidad y el rendimiento de su calzado. Esta exploración de nuevas fronteras tecnológicas ha hecho posible que cada deportista y atleta encuentre en las zapatillas el aliado perfecto para superar sus límites.










El departamento de desarrollo trabaja en profundidad cada día del año para optimizar la ergonomía y el rendimiento del calzado, teniendo en cuenta las necesidades de cada deporte y contando con la colaboración y la experiencia de atletas profesionales. Las exhaustivas pruebas biomecánicas que realizan nuestros profesionales garantizan una mayor comodidad y rendimiento en cada pisada. En el ámbito del running y trail running, estos estudios se enfocan en ofrecer un calzado que proporcione la máxima amortiguación y reactividad con la introducción de sistemas tan novedosos como la placa de fibra de carbono CARBON PLATE, que mejora la eficiencia en carrera mientras el corredor ahorra energía.

ULTRA
DISTANCIA

























MEDIA
DISTANCIA
























CORTA

TECNICIDAD DEL TERRENO + DISTANCIA

TERRENO PEDREGOSO

Este tipo de terrenos se caracterizan por la presencia de piedras sueltas y rocas. Estas superficies exigen suelas robustas y resistente a los impactos, además de contar con una mayor superficie de contacto para optimizar la adherencia a las superficies poco porosas de las rocas.





































TERRENO COMPACTO
Superficies firmes y estables, como senderos de tierra dura, caminos rurales o pistas forestales bien definidas. Este tipo de terreno permite una tracción








































TERRENO GRASO
Este tipo de superficies son blandas y resbaladizas, típicamente cubiertas de barro, hierba mojada o caminos saturados de agua. En este tipo de terreno, la tracción es crítica, por lo que las zapatillas requieren suelas con tacos profundos y separados que permitan expulsar el barro, maximizando el agarre.



































Ofrece las ventajas de una placa de carbono tradicional, como un excelente retorno de energía y una mejora de la eficiencia o un menor desgaste muscular, pero está adaptada pensando en los terrenos irregulares del trail. Su diseño más flexible nos proporciona una estabilidad adicional en superficies técnicas, asegurando un rendimiento óptimo y una mayor confianza en cada paso.




Competición








DROP / 8mm




TACO / 4mm
PESO / 267g



Material ultrarreactivo y ligero, que consigue un excelente retorno de energía para optimizar el rendimiento, reducir la fatiga y ayudar a la recuperación muscular. En las TR-6, este compuesto se combina con una placa de carbono, ideal para corredores que buscan alcanzar la máxima velocidad en sus competiciones.




DISTANCIA / Ultra >50Km
DIFICULTAD TERRENO / Fácil










Tecnología avanzada incorporada en el upper de las zapatillas, mejora la transpirabilidad y el confort, enfocándose en permitir una ventilación óptima, reduciendo la acumulación de calor dentro de la zapatilla. Gracias a sus materiales ligeros y a su diseño especializado, el VTS no solo aligera la zapatilla, sino que también asegura que el pie se mantenga fresco









































































































TKTR6W2501



















TKTR6W2515
























TKTR6W2504





























TKTR6W2505


























TKTR6W2516






TKTR6W2520




























Material ultrarreactivo y ligero, que consigue un excelente retorno de energía para optimizar el rendimiento, reducir la fatiga y ayudar a la recuperación muscular, en las TR-5 esto es esencial para acumular Kilómetros de una manera cómoda pero sin perder ese plus de reactividad y respuesta



USO /















DROP / 5mm



TACO / 4mm





PESO / 296g


DISTANCIA / Ultra >50Km

DIFICULTAD TERRENO / Media-Técnica










La suela cuenta con un taqueado de 4 mm, especialmente diseñado para proporcionar un agarre excepcional en terrenos grasos y técnicos. La profundidad de los tacos asegura una tracción firme en superficies resbaladizas, mientras que el compuesto Durability de alta resistencia garantiza una durabilidad prolongada. Esta suela es Ideal para corredores que enfrentan senderos exigentes, en distancias largas.


Práctico bolsillo integrado en la lengüeta de la zapatilla, diseñado para que guardes cómodamente los cordones. Con este sistema, evitas que se desaten o se enganchen en ramas, rocas u otros obstáculos del camino, brindándote mayor seguridad y comodidad durante tus carreras y entrenamientos












































TKTR5W2504





































TKTR5W2515









































































































TKTR5W2505





TKTR5W2516






































TKTR5W2508



























TKTR5W2520






























MEDALLA BRONCE SKYRUNNING ULTRA 2024











DROP /








Competición-Entrenamiento





TACO / 4,2mm

PESO / 304g

DISTANCIA / Media 40-80Km

DIFICULTAD TERRENO / Medio





La mediasuela de la TR-8 combina dos compuestos para ofrecer un rendimiento excepcional. En la parte trasera, el Fly Reactive proporciona un excelente retorno de energía y una propulsión eficiente, optimizando cada zancada. En la parte delantera, un Phylon de última tecnología aporta mayor estabilidad y reactividad, mejorando el control y la adaptabilidad en cada paso. Estos compuestos garantizan un aterrizaje suave y una respuesta dinámica, brindando un equilibrio perfecto entre comodidad y rendimiento.
La suela de la TR-8 cuenta con un taqueado de 4,2mm, especialmente diseñado para proporcionar un agarre excepcional en terrenos poco porosos como piedra o terrenos húmedos. La profundidad de los tacos asegura una tracción firme y la mayor superficie de contacto nos brinda mayor adherencia en superficies resbaladizas. Además el compuesto Durability de alta resistencia garantiza una durabilidad prolongada.



Sistema compuesto por distintas piezas de TPU situadas en puntos claves de la zapatilla, como la puntera o el puente, protege de los golpes contra rocas, raíces y otros obstáculos del terreno. Esta tecnología no solo protege el pie de impactos no deseados, sino que también refuerza la zapatilla, evitando desgarros y prolongando su durabilidad en terrenos exigentes.





















































MIGUEL HERAS / 2º TRANSGRANCANARIA 2024 (126KM)



















La mediasuela de la TR-7 combina dos compuestos para ofrecer un rendimiento excepcional. En la parte trasera, el Flyreactive proporciona un excelente retorno de energía y una propulsión eficiente, optimizando cada zancada. En la parte delantera, un Phylon de última tecnología aporta mayor estabilidad y reactividad, mejorando el control y la adaptabilidad en cada paso. Estos compuestos garantizan un aterrizaje suave y una respuesta dinámica, brindando un equilibrio perfecto entre comodidad y rendimiento.







DROP / 8mm
TACO /

Competición 3,5mm


PESO / 260g





DISTANCIA / Media 20-50Km






DIFICULTAD TERRENO / Media-Técnica










La suela de la TR-7 cuenta con un taqueado de 3,5 mm, especialmente diseñado para proporcionar un agarre excepcional en terrenos grasos y técnicos. La profundidad de los tacos asegura una tracción firme en superficies resbaladizas, mientras que el compuesto Durability de alta resistencia garantiza una durabilidad prolongada. Esta suela es Ideal para corredores que enfrentan senderos exigentes, en días díficles.







Sistema compuesto por distintas piezas de TPU situadas en puntos claves de la zapatilla, como la puntera o el puente, protege de los golpes contra rocas, raíces y otros obstáculos del terreno. Esta tecnología no solo protege el pie de impactos no deseados, sino que también refuerza la zapatilla, evitando desgarros y prolongando su durabilidad en terrenos exigentes.



































































































TKTR7W2501




















TKTR7W2505

























TKTR7W2506












TKTR7W2515

















TKTR7W2516













TKTR7W2531

















/ 1º CTO. ESPAÑA KM VERTICAL FEDME 2024
















DROP / TACO / PESO /




Competición 6mm 2,75mm 215g





DISTANCIA / Corta <20Km






Material ultrarreactivo y ligero, que consigue un excelente retorno de energía para optimizar el rendimiento, reducir la fatiga y ayudar a la recuperación muscular. En las TR-9, este compuesto logra la máxima ligereza, sin perder en amortiguación, por lo que la hace ideal para corredores que buscan alcanzar la máxima velocidad en sus competiciones.




DIFICULTAD TERRENO / Fácil













Integra una pieza termoplástica en la suela de la zapatilla, diseñada para proporcionar una estabilidad superior. Esta pieza actúa como un soporte adicional, asegurando que la zapatilla mantenga una estructura firme durante las carreras en terrenos variados. Su incorporación optimiza el control y la seguridad, reduciendo el riesgo de torsiones y mejorando la confianza VTS


Tecnología avanzada incorporada en el upper de las zapatillas, mejora la transpirabilidad y el confort, enfocándose en permitir una ventilación óptima, reduciendo la acumulación de calor dentro de la zapatilla. Gracias a sus materiales ligeros y a su diseño especializado, el VTS no solo aligera la zapatilla, sino que también asegura que el pie se mantenga fresco y cómodo durante todo tu entrenamiento o competición.




























































































TKTR9W2501
























TKTR9W2515
































TKTR9W2503



























TKTR9W2505



























TKTR9W2516








TKTR9W2520









































USO / Entrenamiento-Competición





DROP / 8mm













Cuenta con un taqueado de 4,5 mm, especialmente diseñado para proporcionar un agarre excepcional en todo tipo de terrenos. La profundidad de los tacos asegura una tracción firme en todo tipo de superficies, mientras que el compuesto Durability de alta resistencia garantiza una durabilidad prolongada. Esta suela es ideal para corredores que enfrentan todo tipo de terrenos.



TACO / 4,5mm
PESO / 354g














DISTANCIA / Ultra >50Km



DIFICULTAD TERRENO / Media

















































La mediasuela con doble densidad combina el Reactive Ball en la parte trasera, que ofrece una amortiguación excepcional y una absorción de impactos superior. Esta tecnología proporciona un retorno de energía optimizado, reduciendo la presión en cada pisada y maximizando el confort. En la parte delantera, el Phylon de alta calidad asegura una transición suave y una respuesta ágil, además de brindarnos una mayor estabilidad.




Sistema compuesto por distintas piezas de TPU situadas en puntos claves de la zapatilla, como la puntera o el puente, protege de los golpes contra rocas, raíces y otros obstáculos del terreno. Esta tecnología no solo protege el pie de impactos no deseados, sino que también refuerza la zapatilla, evitando desgarros y prolongando su durabilidad en terrenos exigentes.



























































































































































































































































































































DROP / 5mm
TACO / 4mm
PESO / 290g


USO / Entrenamiento-Competición






Cuenta con un taqueado de 4 mm, especialmente diseñado para proporcionar un agarre excepcional en terrenos técnicos. La profundidad de los tacos asegura una tracción firme mientras que el compuesto Durability de alta resistencia garantiza una durabilidad prolongada. Esta suela es Ideal para corredores que enfrentan senderos exigentes.





DISTANCIA / Ultra >50Km


DIFICULTAD TERRENO /


Media-Técnica


















































Diseñado para ofrecer un rendimiento excepcional en cada zancada. Este material innovador proporciona un excelente retorno de energía, adaptándose a la presión y al impacto para brindar una respuesta dinámica y un confort superior. Su estructura de foam reactivo se ajusta a las necesidades del corredor, ofreciendo una amortiguación eficiente y una transición suave entre cada fase de la pisada.

Sistema compuesto por distintas piezas de TPU situadas en puntos claves de la zapatilla, como la puntera o el puente, protege de los golpes contra rocas, raíces y otros obstáculos del terreno. Esta tecnología no solo protege el pie de impactos no deseados, sino que también refuerza la zapatilla, evitando desgarros y prolongando su durabilidad en terrenos exigentes.




































































































































































































































































































































Cuenta con un taqueado de 4,2 mm, especialmente diseñado para proporcionar un agarre excepcional en terrenos muy técnicos. La profundidad de los tacos asegura una tracción firme en todo tipo de superficies, mientras que el compuesto Durability de alta resistencia garantiza una durabilidad prolongada. Esta suela es Ideal para corredores que se enfrentan a terrenos muy técnicos.


DROP / 7mm
TACO / 4,2mm
PESO / 291g


USO / Entrenamiento-Competición







DISTANCIA / Media 20-50Km








DIFICULTAD TERRENO / Técnica





















































Diseñado para ofrecer un rendimiento excepcional en cada zancada. Este material innovador proporciona un excelente retorno de energía, adaptándose a la presión y al impacto para brindar una respuesta dinámica y un confort superior. Su estructura de foam reactivo se ajusta a las necesidades del corredor, ofreciendo una amortiguación eficiente y una transición suave entre cada fase de la pisada.


Sistema compuesto por distintas piezas de TPU situadas en puntos claves de la zapatilla, como la puntera o el puente, protege de los golpes contra rocas, raíces y otros obstáculos del terreno. Esta tecnología no solo protege el pie de impactos no deseados, sino que también refuerza la zapatilla, evitando desgarros y prolongando su durabilidad en terrenos exigentes.




















































TKSIEW2504
































TKSIEW2506






































TKSILW2519























































DROP / 7mm

USO / Entrenamiento-Competición

TACO / 4,2mm
PESO / 304g

















Cuenta con un taqueado de 4,2 mm, especialmente diseñado para proporcionar un agarre excepcional en todo tipo de terrenos. La profundidad de los tacos asegura una tracción firme mientras que el compuesto Durability de alta resistencia garantiza una durabilidad prolongada. Esta suela es Ideal para corredores que se enfrentan a todo tipo de terrenos.






DISTANCIA / Media 20-50Km






DIFICULTAD TERRENO / Media













































Diseñado para ofrecer un rendimiento excepcional en cada zancada. Este material innovador proporciona un excelente retorno de energía, adaptándose a la presión y al impacto para brindar una respuesta dinámica y un confort superior. Su estructura de foam reactivo se ajusta a las necesidades del corredor, ofreciendo una amortiguación eficiente y una transición suave entre cada fase de la pisada.



Tecnología avanzada incorporada en el upper de las zapatillas, mejora la transpirabilidad y el confort, enfocándose en permitir una ventilación óptima, reduciendo la acumulación de calor dentro de la zapatilla. Gracias a sus materiales ligeros y a su diseño especializado, el VTS no solo aligera la zapatilla, sino que



















































































































































































































































































































































































































































































































































































































































- Tejido térmico
- Adaptable a la anatomía corporal
- Antiolor
- Transpirable en zonas estratégicas
- Secado rápido
- Puntos de compresión
- Costuras planas
- Ligereza




































Material térmico diseñado para ofrecer calidez y confort en condiciones frías. A pesar de su capacidad para retener el calor, Brama se destaca por su transpirabilidad, permitiendo la evaporación de la humedad y manteniéndote seco y cómodo durante actividades intensas. Su estructura avanzada equilibra el aislamiento térmico con la ventilación adecuada, asegurando una temperatura óptima del cuerpo sin sobrecalentamiento. Ideal para climas fríos.




Combinación perfecta para optimizar el rendimiento del corredor. Su estructura ultraligera permite una mayor libertad de movimiento, haciendo que cada paso sea más eficiente y menos restrictivo. La compresión estratégica ayuda a reducir la fatiga muscular, mejorando la circulación y acelerando la recuperación. proporcionando al corredor un soporte adicional sin sacrificar la movilidad, ideal para mantener un alto nivel de rendimiento durante las competiciones más exigentes.


Pensada para satisfacer las necesidades del corredor de trail. Ofrece una ligereza ideal para tus entrenamientos y competiciones y detalles prácticos como un cinturón integrado en la mallas para guardar geles, el móvil y otros accesorios esenciales. Diseño enfocado en el corredor que asegura comodidad y funcionalidad durante las carreras, permitiéndote concentrarte en el rendimiento.
























































902434
SEAMLESS SHORT TIGHTS


















902433







SEAMLESS TIGHTS
90%






















- 10000mm Columna de Agua
- 150g
- Costuras termoselladas
- Elementos reflectantes
- Transpirable
- 10000mm Columna de Agua
- 150g
- Costuras termoselladas
- Elementos reflectantes
- Transpirable
- Adaptable a la pierna
- Cremallera
















10,000 mm de columna de agua ofrecen una protección excepcional contra la entrada de agua, manteniéndote seco incluso en condiciones extremas. Esta alta capacidad de impermeabilidad asegura que la prenda sea totalmente resistente al agua, evitando filtraciones en los días más desapacibles. Diseño transpirable que permite la evaporación del sudor y la humedad interna, manteniendo una sensación de confort y frescura. Así, obtienes una combinación ideal de protección contra el agua y regulación de la temperatura.





Prenda diseñada para ocupar poco espacio y ser lo más ligeras posible, lo que las hace ideales para transportar en tu mochila o cinturón de trail. Se pliegan fácilmente, permitiendo una organización compacta. Esta característica facilita su transporte y asegura que siempre tengas a mano una protección confiable sin comprometer el espacio y el peso REFLECTANTE


Ya sea en la oscuridad de un ultra o en una ciudad estas prendas cuentan con elementos reflectantes diseñados para mejorar tu visibilidad. Estos detalles reflectantes aumentan la seguridad, haciéndote más visible para otros corredores, servicios de emergencias o conductores durante tus actividades nocturnas o en ambientes con poca luz. La incorporación de estos elementos en puntos clave de la prenda garantiza una mayor protección, ayudando a prevenir accidentes.










































- Ligereza
- Cortavientos
- Impermeable
- Transpirable




- Elementos reflectantes









































Este cortavientos autoguardable está diseñado para ocupar el mínimo espacio y ser lo más ligero posible, lo que lo hace ideal para transportarlo en tu mochila o cinturón de trail. Se pliega muy fácilmente, permitiendo una organización compacta. Esta característica facilita su transporte y asegura que siempre tengas a mano una protección confiable sin comprometer el espacio y el peso en tu equipo





















Cuenta con zonas de Jacquard transpirable ultraligero estratégicamente ubicadas para mejorar la ventilación y permitir la evaporación del sudor además de dar un plus de elasticidad. Estas áreas de jacquard aseguran que mantengas una temperatura óptima y te sientas cómodo incluso durante esfuerzos intensos. Su diseño combina protección contra el viento con una transpirabilidad mejorada

Está confeccionado con un tejido ultraligero, diseñado para ofrecer una protección eficaz contra el viento sin añadir peso adicional. Este material permite una máxima libertad de movimiento y es fácil de llevar, ya que se pliega de manera compacta para que lo puedas guardar en tu mochila o cinturón




































- Corte láser sin costuras
- Ligereza
- Bolsillo
- Adaptable a la anatomía corporal
- Compresión
- Antideslizante

























Estas mallas están cortadas a láser, eliminando las costuras y garantizando un ajuste suave y sin fricciones. Diseñadas para adaptarse como una segunda piel, no cuentan con cordones ni gomas, lo que permite una adaptación perfecta a todo tipo de cuerpos. Su diseño innovador asegura un ajuste y comodidad excepcional.














Diseñadas con compresión estratégica, que proporciona un soporte adicional a los músculos y mejora la circulación sanguínea. La compresión ayuda a reducir la fatiga y acelerar la recuperación, optimizando el rendimiento durante las carreras. Esta tecnología se integra de manera fluida en el tejido, ofreciendo un ajuste personalizado que se adapta a tu cuerpo mientras te proporciona el soporte necesario.


Bolsillos termosellados, diseñados para guardar de forma segura el móvil, geles y otros elementos esenciales. Estos bolsillos mantienen tus pertenencias protegidas de la humedad y el sudor, sin añadir volumen ni interferir con la libertad de movimiento, ofreciendo una solución práctica y discreta para tus necesidades en el trail.







































































